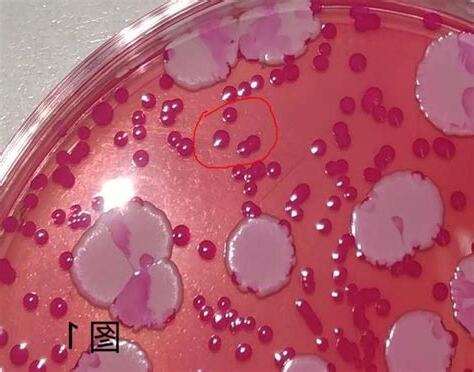
黴菌有哪些

首先,黴菌喜歡在相對濕度50%以上、温度12℃以上的環境中生存。當温度達到20℃以上,且濕度維持在75%以上時,黴菌的生長會更加快速,甚至呈現爆發性增長。而且,塵埃為室內黴菌提供了理想的營養源,助長了它們的生長。因此,浴室和廚房成為黴菌的重災區,因為這些地方通常比較潮濕。
首先,黴菌喜歡在相對濕度50%以上、温度12℃以上的環境中生存。當温度達到20℃以上,且濕度維持在75%以上時,黴菌的生長會更加快速,甚至呈現爆發性增長。而且,塵埃為室內黴菌提供了理想的營養源,助長了它們的生長。因此,浴室和廚房成為黴菌的重災區,因為這些地方通常比較潮濕。

黴菌的種類繁多,從橄欖綠到黑色不等。雖然有些菌種可以用來製造醬料和醬油,但許多黴菌對人體是有害的。當黴菌孢子落在糧食或飼料上,它們可能會產生黃麴毒素,這種毒素進入人體可能會引起類似感冒的過敏反應。

黑色黴菌是家居內外常見的黴菌,它們不僅引起過敏,還可能侵入人體神經系統,導致嚴重的健康問題。這些黴菌喜歡在傢俱、牆壁、油漆表面、磁磚隙縫、雪櫃門墊和塑膠產品中生長。
延伸閲讀…
【回南天】為何春天令黴菌大爆發?瞭解家居常見5種黴菌
生活中常見黴菌有哪些?是否可以從外觀上分辨黴菌呢?
黑色黴菌是家居內外常見的黴菌,它們不僅引起過敏,還可能侵入人體神經系統,導致嚴重的健康問題。這些黴菌喜歡在傢俱、牆壁、油漆表面、磁磚隙縫、雪櫃門墊和塑膠產品中生長。
延伸閲讀…
黴菌- 維基百科
食品中常見的黴菌有哪些?如何解決食品廠車間黴菌污染?
<